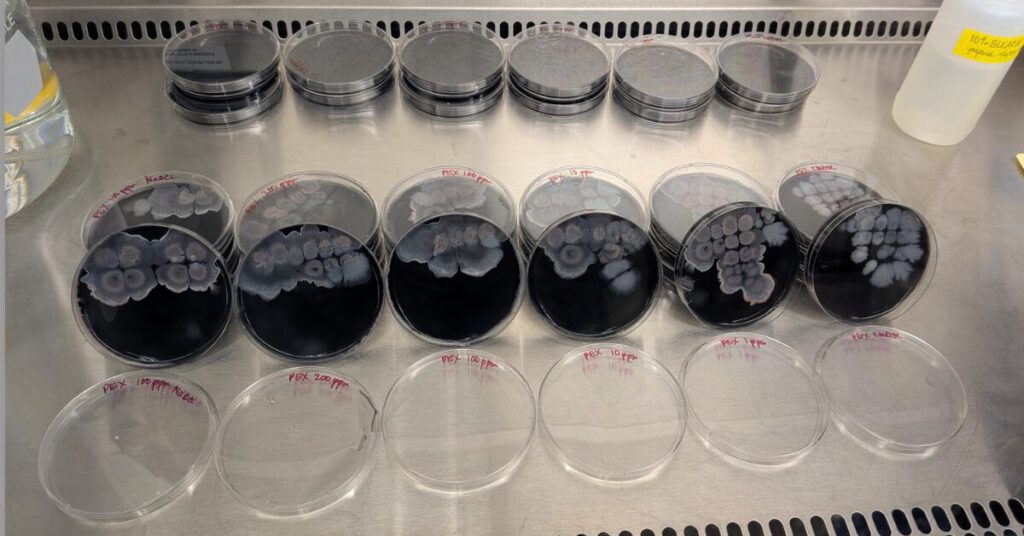

By: Jeff Rogers, MPH
Biofilm has a way of settling into places most people never think about — the bends of a copper line, the seams of a stainless-steel fitting, the pores of HDPE pipe. Once it takes hold, it’s stubborn. Traditional disinfectants skim the surface, leaving the deeper layers untouched, growing, and waiting. Facilities see the symptoms, declining water quality, recurring contamination, and unexplained odors, but the root cause stays hidden.

That’s what drove the work behind the CBE Biofilm Project. Partnering with Montana State University’s Center for Biofilm Engineering, IWC Innovations set out to see what would happen if a different kind of chemistry went up against these entrenched microbial communities. HydroTreat™ wasn’t designed to just sanitize the surface; it was engineered to penetrate, dismantle, and kill biofilm at its core.
The results were hard to ignore. Across stainless steel, copper, and high-density polyethylene (HDPE), HydroTreat™ went deeper and performed better than industrial strength bleach, breaking up biomass that chlorine simply couldn’t fully reach. For many, this research offers the first real glimpse of what it looks like when biofilm is not just managed, but truly defeated.